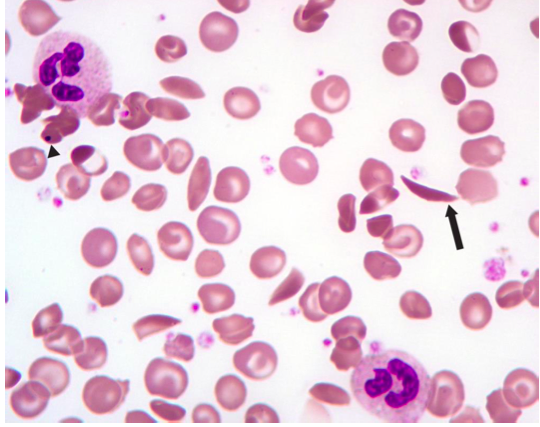

What are the components of plasma?
- water
- electrolytes such as Na, Cl, K, PO4 and HCO3 ions
- glucose, amino acids, immunoglobulin, complement proteins, steroids and clotting factors
What shape are rbcs? Why do rbcs have a pale staining center?
biconcave disc
center of rbc stains pale because there is less material in this thin part
What is the function of the erythrocytes biconcave shape?
maximizes the surface-to-volume ratio facilitating gas exchange
What cytoskeletal elements maintain the erythrocyte’s shape?
spectrin, actin, ankyrin
Based on the shape of these erythrocytes, can you identify this blood disorder?
sicke cell disease
What are the symptoms of sickle cell disease?
- severe anemia
- sickled cells are fragile and lyse
- vaso-occlusive complications
- normal appearing cells whose membranes have been altered by repeated sickling adhere to the endothelium causing narrowing of small vessels which leads to:
- trapping of sickled cells
- vascular occlusion
- ischemic tissue damage which manifests as painful crisis
- normal appearing cells whose membranes have been altered by repeated sickling adhere to the endothelium causing narrowing of small vessels which leads to:
- chronic hyperbilirubinemia
- large amounts of bilirubin in blood. manifests as jaundice
do RBCs have nuclei?
No
What is the lifespan of erythrocytes?
120 days
Some patients may have increased reticulocytes in their peripheral blood indicating an increased demand for erythrocytes. Based on what you’ve learned about the functions of erythrocytes, what conditions might produce the premature release of reticulocytes from the bone marrow into peripheral blood?
reticuloctes may appear in the blood as a result of hemorrhage
loss of rbc’s, anemia
loss of rbc’s ascent to high altitude
increased O2 demand
What is the neutrophil appendage of female neutrophils?
inactive X chromosome (Barr body)
What are 3 substances within specific granules of neutrophils? What about non-specific granules of neutrophils?
- specific (secondary) granules contain alkaline phosphatase, amino peptidase, collagenase, other enzymes
- non-specific (primary) granules are lysosomes containing acid hydrolases, lysozyme, other enzymes;
What are known functions of neutrophils?
neutrophil functions include phagocytosis and destruction of microorganisms and initiation of the inflammatory process
What are 2 functions of eosinophils?
- Eosinophils are increased in number in parasitic worm infections and allergic reactions.
Eosinophils function outside of the circulation in which tissues? Why are eosinophils in the tissue spaces rather than in blood vessels?
Eosinophils can be found in the dermis of the skin and in connective tissue components of the respiratory tree, gastrointestinal tract, uterus and vagina. They are within tissue spaces so that they can encounter foreign microorganisms and antigens.
How might antihistamines affect basophiles?
antihistamines inhibit degranulation of basophils
When monocytes enter peripheral tissues, they differentiate into what?
Macrophages
The larger lymphocytes may be activated B cells which secrete _______
antibodies
Where are platelets derived from?
Platelets are derived from large cells in the bone marrow callded megakaryocytes
What is the function of platelets?
Clotting cascade
How many nuclei are present in platelets? How about megakaryocytes?
platelets: 0 nuclei
megakaryocytes: 1 nuclei
What is the princial symtom of thrombocytopenia?
Thromboctopenia is a condition in which there is an abnormally low number of platelts in the peripheral blood
The principal symptom is mucocutaneous bleeding
What product is synthesized by the polyribosomes in the cells in the early stages of erythrocyte production?
Hemoglobin
Why does the cytoplasm change color as the cell in the erythropoietic series differentiate?
the increase in hemoglobin protein content leads to increased red staining, the decrease in polyribosome (Hb mRNA) content leads to decreased blue staining
How might iron deficiency affect the morphology of erythrocytes?
iron deficiency results in rbcs which are microcytic (smaller than normal) and exibit hypochromasia (less hemoglobin leads to decreased redness in the rbcs; they tend to have staining only at the periphery of the cell due to increased central pallor)







































